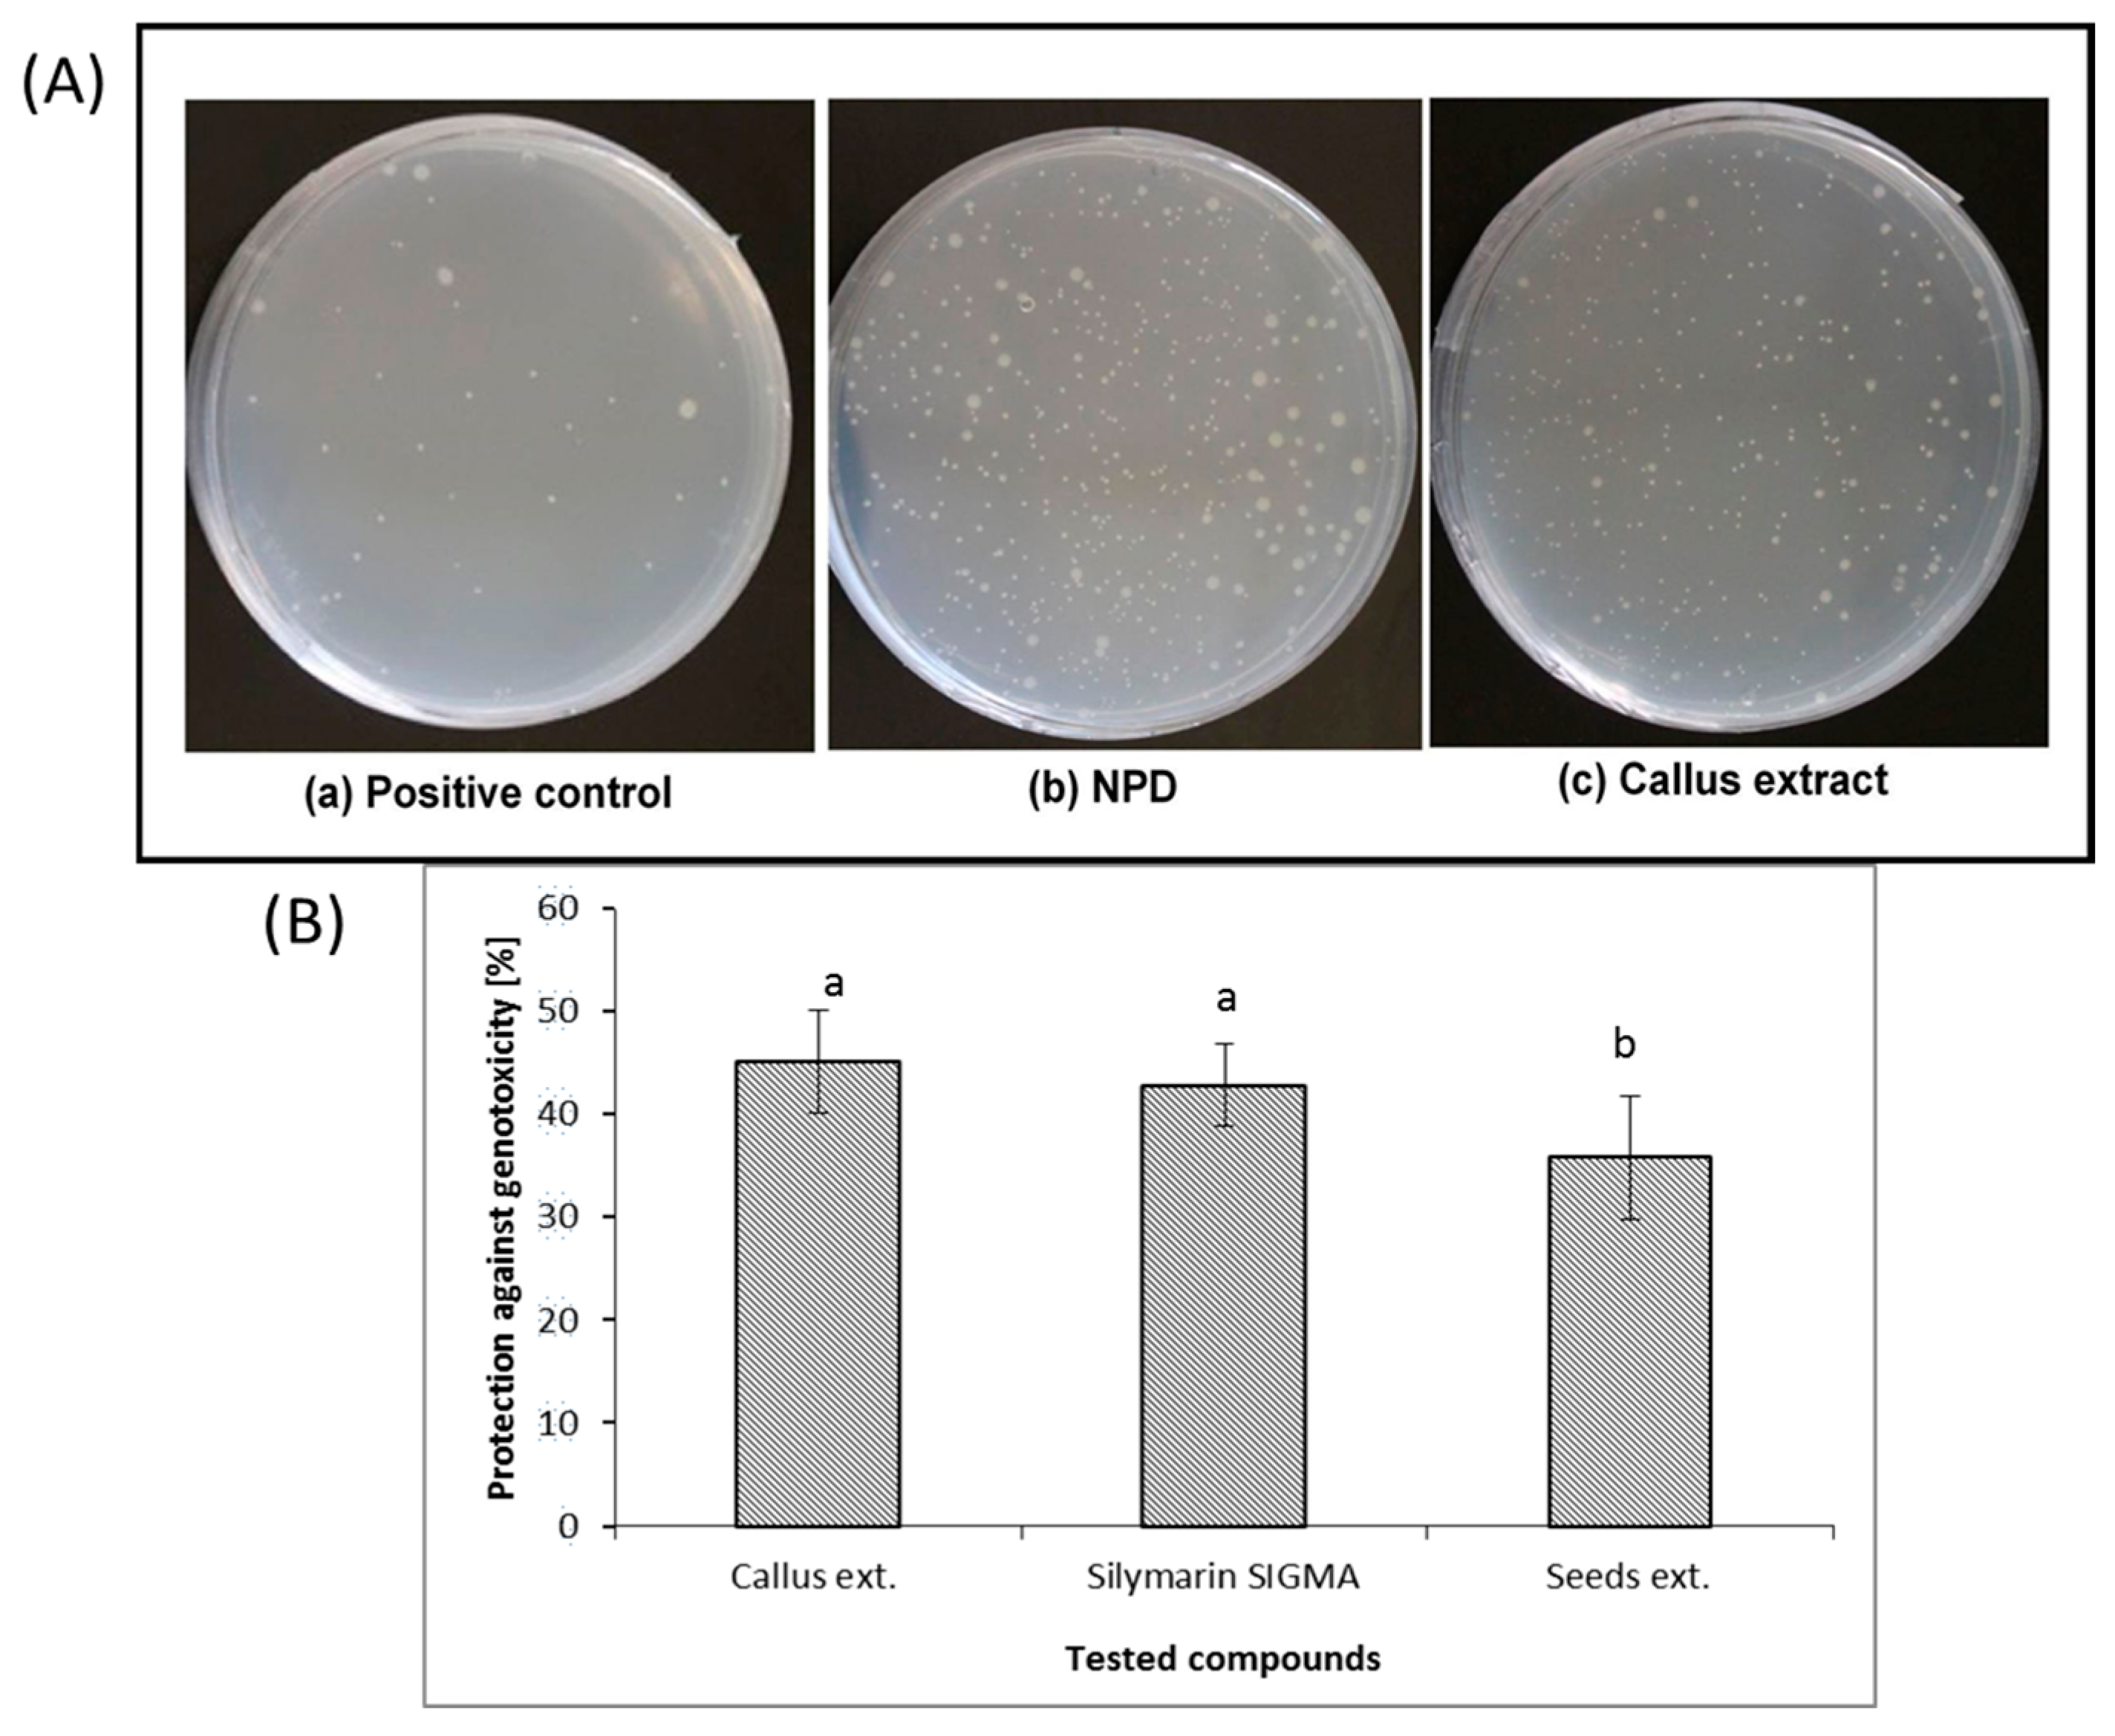
Genes 11 00791 g004 Genes 11 00791 g004

A New Strategy to Increase Production of Genoprotective Bioactive Molecules from Cotyledon-Derived Silybum marianum L. Callus
Abstract
1. Introduction
2. Material and Methods
2.1. Callus Culture
2.2. Callus Extract for Chemical Analysis
2.3. Estimation of Flavonoids
2.4. Estimation of Saponin
2.5. Total Phenolic Compounds
2.6. HPLC Analysis
2.7. Mass Spectrometry
2.8. Bacterial Reverse Mutation Test (Ames Test)
2.9. Statistical Analysis
3. Results and Discussion
3.1. Callus Culture and Production of Flavonoids, Phenolics, and Saponins
3.2. HPLC and Mass Spectrometric Analysis
3.3. Anti-Genotoxicity Effects of Callus Extract
4. Conclusions
Author Contributions
Funding
Acknowledgments
Conflicts of Interest
References
- Boulos, L. Flora of Egypt; Al Hadara Publishing Inc.: Cairo, Egypt, 2000; pp. 125–182. [Google Scholar]
- Parsons, W.T.; Cuthbertson, E.G. Noxious Weeds of Australia, 2nd ed.; Angus & Robertson: Sydney, Australia, 2001. [Google Scholar]
- Svoma, E. Studies on the embryology and gynoecium structures in Drimys winteri (Winteraceae) and some Annonaceae. Plant Syst. Evol. 1998, 21, 205–229. [Google Scholar] [CrossRef]
- Anthony, K.L.; Saleh, M.A. Free Radical Scavenging and Antioxidant Activities of Silymarin Components. Antioxidants 2013, 2, 398–407. [Google Scholar] [CrossRef] [PubMed]
- Pradhan, S.C.; Girish, C. Hepatoprotective herbal drug, silymarin rom experimental pharmacology to clinical medicine. Indian J. Med. Res. 2006, 124, 491–504. [Google Scholar] [PubMed]
- Pepping, J. Milk Thistle: Silybum marianum. Am. J. Health Syst. Pharm. 1999, 56, 1195–1197. [Google Scholar] [CrossRef] [PubMed]
- Riedel, H.; Cai, Z.; Kutuk, O.; Smetanska, I. Obtaining phenolic acids from cell cultures of various Artemisia species. Afr. J. Biotechnol. 2010, 9, 8805–8809. [Google Scholar]
- Kren, V.; Walterova, D. Silybin and silymarin new effects and applications. Biomed. Papers. 2005, 149, 29–41. [Google Scholar] [CrossRef]
- Koksal, E.; Gulcin, I.; Beyza, S.; Sarikaya, O.; Bursal, E. In vitro antioxidant activity of silymarin. J. Enzyme Inhib. Med. Chem. 2009, 24, 395–405. [Google Scholar] [CrossRef]
- Fraschini, F.; Demartini, G.; Esposti, D. Pharmacology of silymarin. Clin. Drug Investig. 2002, 22, 51–65. [Google Scholar] [CrossRef]
- Saller, R.; Meier, R.; Brignoli, R. The use of silymarin in the treatment of liver diseases. Drugs 2001, 61, 2035–2063. [Google Scholar] [CrossRef]
- Singh, R.P.; Aggarwal, R. Prostate cancer prevention by silibinin. Curr. Cancer Drug Targets 2004, 4, 1–11. [Google Scholar] [CrossRef]
- Yang, S.H.; Lin, J.K.; Chen, W.S.; Chiu, J.H. Antiangiogenic effect of silymarin on colon cancer LoVo cell line. J. Surg. Res. 2003, 113, 133–138. [Google Scholar] [CrossRef]
- Sa, G.; Mi, M.; He-chun, Y.; Ben-ye, L.; Guo-Feng, L.; Kang, C. Effect of ipt gene expression on the physiological and chemical characteristics of Artemisia annua L. Plant. Sci. 2001, 160, 691–698. [Google Scholar] [CrossRef]
- Bonhomme, V.; Laurain-Matter, D.; Lacoux, J.; Fliniaux, M.A.; Jacquin-Dubreuil, A. Tropane alkaloid production by hairy roots of Atropa belladonna obtained after transformation with Agrobacterium rhizogenes15834 and Agrobacterium tumefaciens containing rol A, B, C genes only. J. Biotechnol. 2000, 81, 151–158. [Google Scholar] [CrossRef]
- Cacho, M.; Moran, M.; Corchete, P.; Fernandez-Tarrago, J. Influence of medium composition on the accumulation of flavonolignans in cultured cells of Silybum marianum (L.) Gaertn. Plant. Sci. 1999, 144, 63–68. [Google Scholar] [CrossRef]
- Hagendoorn, M.J.M.; Wagner, A.M.; Segers, G.; Van der Plas, L.H.W.; Oostdam, A.; Van Walraven, H.S. Cytoplasmic acidification and secondary metabolite production in different plant cell suspensions. Plant. Physiol. 1994, 106, 723–730. [Google Scholar] [CrossRef]
- Cimino, C.; Cavalli, S.V.; Spina, F.; Natalucci, C.; Priolo, N. Callus culture for biomass production of Milk thistle as a potential source of milk clotting peptidases. Electron. J. Biotechnol. 2006, 9, 238–240. [Google Scholar] [CrossRef]
- Doernenburg, H.; Knorr, D. Strategies for the improvement of secondary metabolite production in plantcell cultures. Enzym. Microb. Technol. 1995, 17, 674–684. [Google Scholar] [CrossRef]
- Shah, S.M.M.; Khan, F.A.; Shah, S.M.H.; Chishti, K.A.; Pirzada, S.M.S.S.; Khan, M.A. Evaluation of phytochemicals and antimicrobial activity of white and blue capitulum and whole plant of Silybum marianum. World Appl. Sci. J. 2011, 12, 1139–1144. [Google Scholar]
- Ahmed John, S.; Koperuncholan, M. Direct Root Regeneration and Indirect Organogenesis in Silybum marianum and Preliminary Phytochemical, Antibacterial Studies of Its Callus. Int. J. Pharm. 2012, 2, 52–57. [Google Scholar]
- Huang, Q.F.; Zhang, S.J.; Zheng, L.; He, M.; Huang, R.B.; Lin, X. Hepatoprotective effects of total saponins isolated from Taraphochlamys affinis against carbon tetrachloride induced liver injury in rats. Food Chem. Toxicol. 2012, 50, 713–718. [Google Scholar] [CrossRef]
- Rastogi, S.; Pandey, M.M.; Rawat, A.K.S. An ethnomedicinal, phytochemical and pharmacological profile of Desmodium gangeticum (L.) DC. and Desmodium adscendens (Sw.) DC. J. Ethnopharmacol. 2011, 136, 283–296. [Google Scholar] [CrossRef] [PubMed]
- Qu, L.P.; Xin, H.L.; Zheng, G.Y. Hepatoprotective activity of the total saponins from Actinidia valvata dunn root against carbon tetrachloride-induced liver damage in mice. Evid.-Based Complement. Alternat. Med. 2012, 216061, 1–13. [Google Scholar] [CrossRef] [PubMed]
- Zhang, Y.N.; Liu, L.; Ling, C.Q. Inhibition effect of active fraction from Actinidia valvata on growth of transplanated mouse tumor cells and preliminary study of its mechanism. Zhongguo Zhongyao Zazhi 2006, 31, 918–920. [Google Scholar] [PubMed]
- Yi, T.J.; Xu, Y.F.; Zheng, G.; Zheng, Y.; Xin, H.L.; Ling, C.Q. Inhibitory effects of total saponin from Actinidia Valvata on murine transplanted tumor. Chin. Arch. Tradit. Chin. Med. 2009, 27, 1642–1643. [Google Scholar]
- Murthy, H.N.; Dandin, V.S.; Zhong, J.J.; Paek, K.Y. Strategies for enhanced production of plant secondary metabolites from cell and organ cultures. In Production of Biomass and Bioactive Compounds Using Bioreactor Technology; Paek, K.Y., Murthy, H.N., Zhong, J.J., Eds.; Springer: Dordrecht, The Netherlands, 2014; pp. 471–508. [Google Scholar]
- Moreno, P.R.H.; van der Heijden, R.; Verpoorte, R. Cell and tissue cultures of Catharanthus Roseus: A literature survey. Plant. Cell Tissue Organ. Cult. 1995, 42, 1–25. [Google Scholar] [CrossRef]
- Clifford, M.N.; Kirkpatrick, J.; Kuhnert, N.; Roorendaal, H.; Salgado, P.R. LC-MSn analysis of the cis isomers of chlorogenic acids. Food Chem. 2008, 106, 379–385. [Google Scholar] [CrossRef]
- Kim, J.; Jeong, I.H.; Kim, C.S.; Lee, Y.M.; Kim, J.M.; Kim, J.S. Chlorogenic acid inhibits the formation of advanced glycation end products and associated protein cross-linking. Arch. Pharm. 2011, 3, 495–500. [Google Scholar] [CrossRef]
- Yang, J.S.; Liu, C.W.; Ma, Y.S.; Weng, S.W.; Tang, N.Y.; Wu, S.H.; Ji, B.C.; Ma, C.Y.; Ko, Y.C.; Funayama, S.; et al. Chlorogenic Acid Induces Apoptotic Cell Death in U937 Leukemia Cells through Caspase- and Mitochondria-dependent Pathways. In Vivo 2012, 26, 971–978. [Google Scholar]
- Kidd, P.M. Bioavailability and activity of phytosome complexes from botanical polyphenols: The silymarin, curcumin, green tea, and grape seed extracts. Altern. Med. Rev. 2009, 14, 226–246. [Google Scholar]
- Mortelmans, K.; Zeiger, E. The Ames Salmonella/microsome mutagenicity assay. Mutat. Res. 2000, 455, 29–60. [Google Scholar] [CrossRef]
- Aydin, S.; Basaran, A.A.; Basaran, N. The protective effects of some phenylethanoid glycosides on the mitomycin c induced DNA strand breakage. Hacet. Univ. J. Fac. Pharm. 2004, 24, 1–11. [Google Scholar]
- Ames, B.N.; McCann, J.; Yamasaki, E. Methods for detecting carcinogens and mutagens with the Salmonella/mammalian-microsome mutagenicity test. Mutat. Res. 1975, 31, 347–364. [Google Scholar] [CrossRef]
- McCann, J.; Spingarn, N.E.; Kobori, J.; Ames, B.N. Detection of carcinogens as mutagens: Bacterial tester strains with R factor plasmids. Proc. Natl. Acad. Sci. USA 1975, 72, 979–983. [Google Scholar] [CrossRef]
- Chang, C.C.; Yang, M.H.; Wen, H.M.; Chern, J.C. Estimation of total flavonoid content in propolis by two complementary colorimetric methods. J. Food Drug Anal. 2002, 10, 178–182. [Google Scholar]
- Hiai, S.; Oura, H.; Hamanaka, H.; Odaka, Y. A colour reaction of panaxadiol with vanillin and sulfuric acid. Planta Med. 1975, 28, 131–138. [Google Scholar] [CrossRef] [PubMed]
- Jindal, K.K.; Singh, R.N. Phenolic content in male and female Carica papaya: A possible physiological marker for sex identification of vegetable seedlings. Physiol. Plant. 1975, 33, 104–107. [Google Scholar] [CrossRef]
- Maron, D.; Ames, B.N. Revised methods for the Salmonella mutagenicity test. Mutat. Res. 1983, 113, 173–215. [Google Scholar] [CrossRef]
- Bishop, O.N. Statistics in Biology; Longman, Penguin: London, UK, 1983; pp. 56–63. [Google Scholar]
- Elhaak, M.; Zayed, M.; Mattar, M.; Gad, D.A.; Dietz, K.J. Optimization of Silybum marianum L. callus production and magnifying callus silymarin accumulation by elicitors or precursors. Int. J. Adv. Pharm. Biol. Chem. 2016, 5, 148–163. [Google Scholar]
- Stafford, A.; Morris, P.; Fowler, M.W. Plant cell biotechnology: A perspective. Enzym. Microb. Technol. 1986, 8, 19–23. [Google Scholar] [CrossRef]
- Namdeo, A.; Patil, S.; Fulzele, D.P. Influence of fungal elicitors on production of Ajmalicine by cell cultures of Catharanthus roseus. Biotechnol. Prog. 2002, 18, 159–162. [Google Scholar] [CrossRef]
- Monemi, M.B.; Kazemitabar, S.K.; Khaniki, B.G.; Yasari, E.; Sohrevardi, F.; Pourbagher, R. Tissue culture study of the medicinal plant leek (Allium ampeloprasum L.). Int. J. Mol. Cell. Med. 2014, 3, 119–125. [Google Scholar]
- Liu, M.C. Factors affecting induction, Somatic embryogenesis and Plant regeneration of calli from culture immature inflourescence of Sugarcane. J. Plant. Physiol. 1993, 141, 714–720. [Google Scholar] [CrossRef]
- Mordhorst, A.P.; Voerman, K.J.; Hartog, M.V.; Meijer, E.A.; Vanwent, J.; Koornneef, M.; Devries, S.C. Somatic embryogenesis in Arabidopsis thaliana is facilitated by mutations in genes repressing meristematic cell divisions. Genetics 1998, 149, 549–563. [Google Scholar] [PubMed]
- Benson, E.E. In vitro plant recalcitrance, an introduction. In Vitro Cell. Dev. Biol. Plant. 2000, 36, 141–148. [Google Scholar] [CrossRef]
- Kavasnica, F.; Biba, B.; Sevcik, R.; Voldrich, M.; Kratkta, J. Analysis of active components of silymarin. J. Chromatogr. A 2003, 990, 239–245. [Google Scholar] [CrossRef]
- Kuki, A.; Nagy, L.; Deak, G.; Nagy, M.; Zsuga, M.; Keki, S. Identification of silymarin constituents: An improved HPLC-MS method. Chromatographia 2012, 75, 175–180. [Google Scholar] [CrossRef]
- Li, Z.; Wang, L.; Yang, G.; Shi, H.; Jiang, C.; Liu, W.; Zhang, Y. Study on the determination of polyphenols in Tobacco by HPLC coupled with ESI-MS after solid-phase extraction. J. Chromatogr. Sci. 2003, 41, 36–40. [Google Scholar] [CrossRef]
- Plazonic, A.; Bucar, F.; Males, Z.; Mornar, A.; Nigovic, B.; Kujundzic, N. Indentification and quantification of flavonoids and phenolic acids in Burr Parsely (Caucalis platycarpos L.) using high performance liquid chromatography with Diode array detection and electrospray ionization mass spectrometry. Molecules 2009, 14, 2466–2490. [Google Scholar] [CrossRef]
- Niggeweg, R.; Michael, A.J.; Martin, C. Engineering plants with increased levels of the antioxidant chlorogenic acid. Nat. Biotechnol. 2004, 22, 746–754. [Google Scholar] [CrossRef]
- Kapil, A.; Koul, I.B.; Suri, O.P. Antihepatotoxic effects of chlorogenic acid from Anthocephalus cadamba. Phytother. Res. 1995, 9, 189–193. [Google Scholar] [CrossRef]
- Wu, Y.H.; Hao, B.J.; Shen, E.; Meng, Q.L.; Hu, M.H.; Zhao, Y. Protective properties of Laggera alata extract and its principle components against D-Galactosamine-injured Hepatocytes. Sci. Pharm. 2012, 80, 447–456. [Google Scholar] [CrossRef]
- Stoiljkavic, Z.Z.; Petrovic, S.D.; Ilic, B.S. Examination of localization of silymarin and fatty oil in Silybum marianum Gaertn. fruit. Chem. Ind. Chem. Eng. Q. 2007, 13, 55–59. [Google Scholar] [CrossRef]
- Chan, R.I.; San, R.H.; Stich, H.F. Mechanism of Inhibition of N-methyl-N’-nitro-N-nitrosoguanidine-induced Mutagenesis by Phenolic Compounds. Cancer Lett. 1986, 31, 27–34. [Google Scholar] [CrossRef]
- Yoshimoto, M.; Yahara, S.; Okuno, S.; Islam, S.; Ishiguro, K.; Yamakawa, O. Antimutagenicity of mono-, di-, and tricaffeoylquinic acid derivatives isolated from sweet potato (Ipomoea batatas L.) leaf. Biosci. Biotechnol. Biochem. 2002, 66, 2336. [Google Scholar] [CrossRef]
- Toyoda-Hokaiwado, N.; Yasui, Y.; Muramatsu, M.; Masumura, K.; Takamune, M.; Yamada, M.; Ohta, T.; Tanaka, T.; Nohmi, T. Chemopreventive effects of silymarin against 1,2-dimethylhydrazine plus dextran sodium sulfate-induced inflammation-associated carcinogenicity and genotoxicity in the colon of gpt delta rats. Carcinogenesis 2011, 32, 1512–1517. [Google Scholar] [CrossRef] [PubMed]
- De Flora, S. Mechanisms of inhibitors of mutagenesis and carcinogenesis. Mutat. Res. 1998, 402, 151–158. [Google Scholar] [CrossRef]
- De Flora, S.; Izzoti, A.; Agostini, D.F.; Balansky, B.M.; Noonan, D.; Albini, A. Multiple points of intervention in the prevention of cancer and other mutation-related diseases. Mutat. Res. 2001, 480, 9–22. [Google Scholar] [CrossRef]

| 2,4-D (mg/L) | Asparagine (mg/L) | Benzyladenine (mg/L) | Myo-Inositol (mg/L) | |||||||||
|---|---|---|---|---|---|---|---|---|---|---|---|---|
| 0.0 | 25 | 50 | 100 | 0.0 | 0.01 | 0.05 | 0.1 | 0.0 | 25 | 50 | 100 | |
| 0.0 | 0 | A | B | C | 0 | A | B | C | 0 | A | B | C |
| 0.25 | D | E | F | G | D | E | F | G | D | E | F | G |
| 0.5 | H | I | J | K | H | I | J | K | H | I | J | K |
| 1.0 | L | M | N | O | L | M | N | O | L | M | N | O |
| Growth Regulators Level (mg/L) | Flavonoids | Phenolic Compounds | Saponin | Total | ||||
|---|---|---|---|---|---|---|---|---|
| Media Code | 2,4-D | Asn | BAP | Inositol | (mg/g dw) | |||
| A | 0 | 25 | 0.01 | 25 | NI | NI | NI | NI |
| B | 0 | 50 | 0.05 | 50 | 1.4 ± 0.2 c | 5 ± 0.6 bc | 33 ± 1 ab | 39.4 |
| C | 0 | 100 | 0.1 | 100 | 4.2 ± 0.2 fg | 13 ± 0.9 hi | 32 ± 2 ab | 49.2 |
| D | 0.25 | 0 | 0 | 0 | 1.6 ± 0.2 c | 4 ± 0.7 ab | 24 ± 2 ab | 29.6 |
| E | 0.25 | 25 | 0.01 | 25 | 4.4 ± 0.3 g | 14 ± 0.3 i | 33 ± 2 ab | 51.4 |
| F | 0.25 | 50 | 0.05 | 50 | 4.7 ± 0.3 g | 16 ± 0.8 j | 42 ± 5 b | 62.7 |
| G | 0.25 | 100 | 0.1 | 100 | 2.6 ± 0.1 d | 10 ± 1 g | 33 ± 2 ab | 35.6 |
| H | 0.5 | 0 | 0 | 0 | 0.7 ± 0.03 ab | 3 ± 0.7 a | 26 ± 1 ab | 29.7 |
| I | 0.5 | 25 | 0.01 | 25 | 4.2 ± 0.4 fg | 12 ± 2.2 h | 32 ± 1 ab | 48.2 |
| J | 0.5 | 50 | 0.05 | 50 | 3.8 ± 0.2 ef | 12 ± 1.1 gh | 53 ± 9 e | 68.8 |
| K | 0.5 | 100 | 0.1 | 100 | 3.4 ± 0.1 e | 10 ± 1.6 g | 52 ± 16 e | 65.4 |
| L | 1 | 0 | 0 | 0 | 1.7 ± 0.03 c | 4 ± 1.4 ab | 27 ± 7 c | 31.0 |
| M | 1 | 25 | 0.01 | 25 | 2.4 ± 0.1 d | 9 ± 1.2 f | 43 ± 4 d | 54.4 |
| N | 1 | 50 | 0.05 | 50 | 1.3 ± 0.2 bc | 8 ± 0.5 ef | 46 ± 20 d | 55.3 |
| O | 1 | 100 | 0.1 | 100 | 1.2 ± 0.2 bc | 6 ± 0.7 cd | 42 ± 2 b | 49.2 |
| Mean content in callus | 2.8 ± 1.5 | 9.0 ± 2.1 | 36.3 ± 2 | 48.1 | ||||
| Mean content in seeds | 0.6 ± 0.03 | 6 ± 0.5 | 12 ± 4 | 18.6 | ||||
| F-value | 50.24 | 60.27 | 171.3 | |||||
| Probability p< | 0.00 | 0.00 | 0.00 | |||||
| Peak 1: MS1 353, MS/MS 190.1 | Peak 2: MS1 515.1, MS/MS 352.9 | |||
|---|---|---|---|---|
| Media Code | TR (min) | Chlorogenic Acid (mg/g DW) | TR (min) | Dicaffeoylquinic Acid (mg/g DW) |
| A | NI | NI | NI | NI |
| B | 7.9 | 3.7 ± 1.1 bcde | 17.4 | 5.0 ± 1.6 abc |
| C | 7.9 | 6.3 ± 1.1 ef | 17.4 | 9.1 ± 2.5 cde |
| D | 7.9 | 3.5 ± 0.9 bcd | 17.2 | 3.5 ± 1.1 ab |
| E | 7.8 | 3.9 ± 1.0 cde | 17.2 | 10.7 ± 2.5 de |
| F | 7.8 | 4.2 ± 1.4 cde | 17.2 | 9.2 ± 1.7 cde |
| G | 7.8 | 1.7 ± 1.0 abc | 17.2 | 5.4 ± 1.6 abc |
| H | 7.7 | 0.8 ± 0.3 a | 17.1 | 1.7 ± 0.5 a |
| I | 7.7 | 7.2 ± 1.3 f | 17.1 | 11.3 ± 1.8 e |
| J | 7.7 | 5.2 ± 0.6 def | 17.1 | 6.1 ± 2.3 e |
| K | 7.7 | 2.2 ± 0.6 abc | 17.1 | 6.0 ± 1.4 abcd |
| L | 7.7 | 1.1 ± 0.5 ab | 17.1 | 2.5 ± 1.0 ab |
| M | 7.7 | 3.8 ± 0.8 cde | 17.0 | 7.2 ± 2.5 bcde |
| N | 7.7 | 1.8 ± 0.4 abc | 17.0 | 2.9 ± 0.6 ab |
| O | 7.7 | 2.4 ± 0.9 abc | 17.0 | 2.5 ± 0.9 ab |
| Mean | 7.8 | 3.41 | 17.2 | 5.94 |
© 2020 by the authors. Licensee MDPI, Basel, Switzerland. This article is an open access article distributed under the terms and conditions of the Creative Commons Attribution (CC BY) license (http://creativecommons.org/licenses/by/4.0/).
Share and Cite
Gad, D.; Elhaak, M.; Pompa, A.; Mattar, M.; Zayed, M.; Fraternale, D.; Dietz, K.-J. A New Strategy to Increase Production of Genoprotective Bioactive Molecules from Cotyledon-Derived Silybum marianum L. Callus. Genes 2020, 11, 791. https://doi.org/10.3390/genes11070791
Gad D, Elhaak M, Pompa A, Mattar M, Zayed M, Fraternale D, Dietz K-J. A New Strategy to Increase Production of Genoprotective Bioactive Molecules from Cotyledon-Derived Silybum marianum L. Callus. Genes. 2020; 11(7):791. https://doi.org/10.3390/genes11070791
Chicago/Turabian StyleGad, Dina, Mahmoud Elhaak, Andrea Pompa, Magdy Mattar, Mohamed Zayed, Daniele Fraternale, and Karl-Josef Dietz. 2020. "A New Strategy to Increase Production of Genoprotective Bioactive Molecules from Cotyledon-Derived Silybum marianum L. Callus" Genes 11, no. 7: 791. https://doi.org/10.3390/genes11070791
APA StyleGad, D., Elhaak, M., Pompa, A., Mattar, M., Zayed, M., Fraternale, D., & Dietz, K.-J. (2020). A New Strategy to Increase Production of Genoprotective Bioactive Molecules from Cotyledon-Derived Silybum marianum L. Callus. Genes, 11(7), 791. https://doi.org/10.3390/genes11070791

